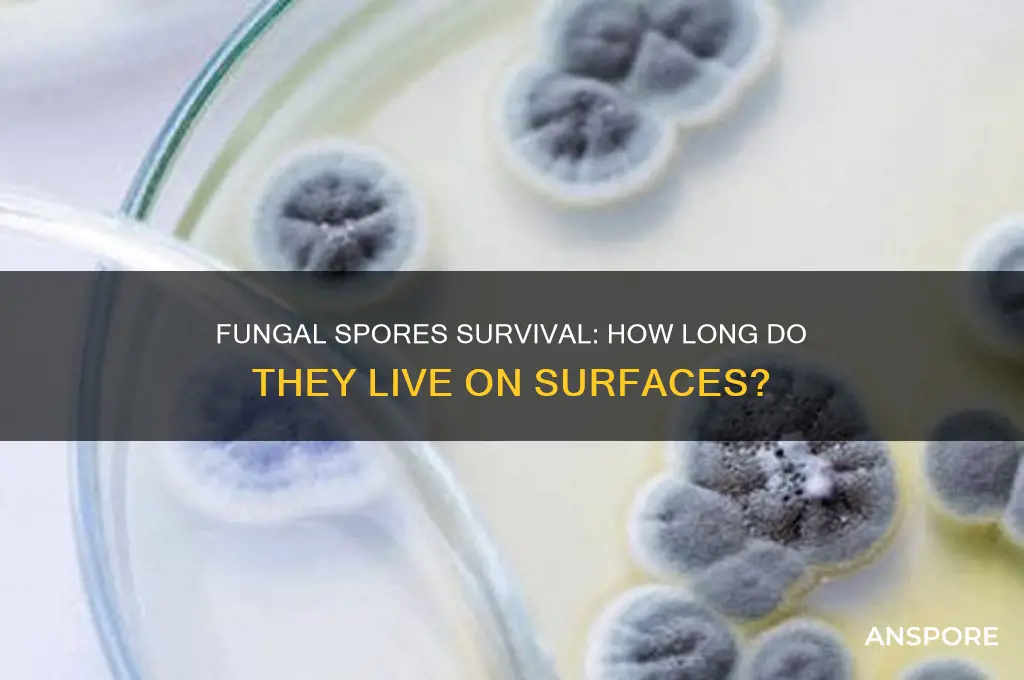
how long do fungal spores live on surfaces

Fungal spores are remarkably resilient microorganisms capable of surviving on various surfaces for extended periods, often ranging from weeks to years, depending on environmental conditions. Factors such as humidity, temperature, light exposure, and surface material significantly influence their longevity. For instance, spores thrive in damp, dark environments and can persist longer on porous materials like wood or fabric compared to non-porous surfaces like metal or glass. Understanding how long fungal spores can remain viable on surfaces is crucial for preventing mold growth, managing indoor air quality, and mitigating health risks, especially in settings like homes, hospitals, and workplaces. Effective cleaning and disinfection strategies are essential to eliminate these spores and reduce their potential to germinate and cause infections or structural damage.
| Characteristics | Values |
|---|---|
| Survival Time on Surfaces | Can survive for weeks to months, depending on environmental conditions |
| Optimal Conditions for Survival | High humidity, warmth, and organic material |
| Survival in Dry Conditions | Can remain viable for years in dry, dormant states |
| Effect of Temperature | Higher temperatures can reduce viability, but some spores are heat-tolerant |
| Impact of UV Light | UV light can reduce spore viability over time |
| Survival on Porous vs. Non-Porous Surfaces | Survive longer on porous surfaces (e.g., wood, fabric) than non-porous (e.g., metal, glass) |
| Common Fungal Spores | Aspergillus, Penicillium, Cladosporium, and Alternaria are known for long-term survival |
| Disinfection Effectiveness | Many disinfectants can kill spores, but effectiveness varies by type and concentration |
| Role of Air Circulation | Poor air circulation can prolong spore survival |
| Cross-Contamination Risk | Spores can easily spread via air, dust, or contact with contaminated surfaces |
Explore related products
$13.48 $14.13
$18.47 $25.87
What You'll Learn
- Surface Material Impact: Different materials affect spore survival duration, from porous to non-porous surfaces
- Environmental Conditions: Humidity, temperature, and light influence how long spores remain viable
- Fungal Species Variation: Survival times differ among species like mold, mildew, or yeast
- Cleaning Effectiveness: Proper cleaning methods reduce spore lifespan on surfaces significantly
- Indoor vs. Outdoor Survival: Spores live longer indoors due to controlled, stable environments

Surface Material Impact: Different materials affect spore survival duration, from porous to non-porous surfaces
Fungal spores' survival on surfaces isn't a one-size-fits-all scenario. The material they land on plays a critical role in determining how long they remain viable. Porous surfaces, like fabric, wood, or carpet, provide nooks and crannies where spores can embed themselves, shielding them from environmental factors like UV light and desiccation. This protective environment allows spores to persist for weeks, months, or even years, depending on the specific fungus and conditions. Non-porous surfaces, such as glass, metal, or plastic, offer fewer hiding spots, exposing spores to harsher conditions that can reduce their lifespan to days or weeks.
Consider a practical example: a mold spore lands on a wooden windowsill versus a stainless steel countertop. On the wood, the spore can burrow into the grain, accessing moisture and nutrients, potentially remaining viable for months. On the steel, the spore is exposed, vulnerable to cleaning agents and air circulation, likely dying within days. This contrast highlights the importance of surface material in spore survival. For instance, in healthcare settings, non-porous surfaces are preferred for high-touch areas to minimize fungal persistence, while in homes, porous materials like upholstery may require more frequent cleaning to prevent spore accumulation.
To mitigate fungal spore survival, tailor your approach to the surface material. For porous surfaces, deep cleaning with fungicidal agents is essential, as spores can penetrate beyond the surface. Steam cleaning carpets or using HEPA vacuums can dislodge embedded spores. Non-porous surfaces benefit from regular disinfection with EPA-approved fungicides, ensuring spores are neutralized before they germinate. For example, a 1:10 bleach solution (1 part bleach to 9 parts water) is effective on non-porous surfaces but may damage porous materials. Always test cleaning agents on a small area first to avoid damage.
The age and condition of the material also influence spore survival. Older, worn surfaces, whether porous or non-porous, may have micro-cracks or irregularities that provide shelter for spores. For instance, an aged wooden floor may harbor spores longer than a newly sealed one. Similarly, scratched metal surfaces can trap spores more effectively than smooth ones. Regular maintenance, such as refinishing wood or replacing worn items, can reduce spore persistence. In high-risk environments like hospitals or mold-prone basements, choosing non-porous, easy-to-clean materials is a proactive measure to limit fungal growth.
Understanding the interplay between surface material and spore survival empowers you to create environments less hospitable to fungi. For porous materials, focus on thorough, periodic cleaning and consider treatments like antimicrobial sprays. For non-porous surfaces, consistency in disinfection is key. By selecting materials wisely and maintaining them properly, you can significantly reduce the risk of fungal spores becoming a persistent problem. This knowledge isn’t just theoretical—it’s a practical tool for healthier living and working spaces.
How Spores Retain Moisture: Survival Strategies in Dry Environments
You may want to see also

Environmental Conditions: Humidity, temperature, and light influence how long spores remain viable
Fungal spores are remarkably resilient, but their survival on surfaces is not a fixed timeline. Environmental conditions act as a dynamic trio, dictating whether spores thrive, languish, or perish. Humidity, temperature, and light each play a distinct role in this microbial drama, influencing spore viability in ways both predictable and surprising.
Humidity reigns supreme in the spore survival saga. Think of spores as tiny, dormant plants – they need moisture to activate and grow. High humidity, above 70%, provides the ideal environment for spore germination. In damp environments, like bathrooms or basements, spores can remain viable for months, even years. Conversely, dry conditions below 50% humidity act as a spore suppressant, significantly shortening their lifespan. For example, a study found that Aspergillus spores, common indoor fungi, lost viability within days when exposed to low humidity levels.
Temperature acts as a double-edged sword. While extreme heat can be detrimental, spores often tolerate a wide range of temperatures. Some fungi, like those causing athlete's foot, thrive in warm environments (25-30°C), while others prefer cooler temperatures (15-20°C). Interestingly, freezing temperatures don't always kill spores; they can simply enter a dormant state, ready to revive when conditions improve. This explains why fungal outbreaks can occur after periods of cold weather.
Understanding these environmental factors empowers us to control spore survival. To minimize fungal growth, maintain indoor humidity below 50% using dehumidifiers, especially in prone areas. Regularly clean and dry surfaces, particularly in damp environments. When dealing with moldy materials, ensure proper ventilation and consider using protective gear to avoid spore inhalation.
Light, often overlooked, also plays a role. Ultraviolet (UV) radiation from sunlight can be a spore's nemesis, damaging their DNA and rendering them non-viable. This is why sunlight is a natural disinfectant, effectively reducing spore populations on surfaces exposed to direct sunlight. However, not all fungi are equally susceptible to UV light, and prolonged exposure is often needed for complete eradication. Combining sunlight with other control measures, like cleaning and dehumidification, offers a more comprehensive approach to spore management.
Can Tetanus Spores Survive in Oxygen? Unraveling the Myth
You may want to see also

Fungal Species Variation: Survival times differ among species like mold, mildew, or yeast
Fungal spores exhibit remarkable resilience, but their survival times on surfaces vary significantly depending on the species. For instance, Aspergillus spores, commonly associated with mold, can persist on surfaces for several months, thriving in environments with moderate humidity and organic matter. In contrast, Penicillium, another mold species, typically survives for weeks to months, though its longevity is influenced by temperature and moisture levels. Understanding these differences is crucial for effective cleaning and prevention strategies, as each species requires tailored approaches to eradication.
Consider yeast, a fungal species often overlooked in surface survival discussions. Unlike mold and mildew, yeast spores (such as those from *Candida*) can remain viable on surfaces for only a few days to weeks. However, their ability to form biofilms enhances their resistance to cleaning agents, making them particularly challenging in healthcare settings. For example, *Candida albicans* spores can survive on medical equipment for up to 14 days, posing infection risks if not properly disinfected. To combat this, use alcohol-based disinfectants with at least 70% concentration, which are proven effective against yeast spores.
Mildew, often confused with mold, has its own unique survival characteristics. Cladosporium, a common mildew species, can persist on surfaces for weeks to months, especially in damp environments like bathrooms or basements. Its lightweight spores are easily dispersed, increasing the likelihood of cross-contamination. To mitigate mildew survival, maintain indoor humidity below 50% and regularly clean surfaces with a solution of 1:10 bleach to water. This not only kills existing spores but also inhibits future growth by removing their food source.
The survival times of fungal spores are also influenced by surface type. Porous materials like wood or fabric provide more hiding places for spores, allowing them to evade cleaning efforts. For example, Trichoderma, a mold species, can penetrate porous surfaces and remain dormant for months, reactivating when conditions improve. Non-porous surfaces like glass or metal, however, are easier to clean but may still harbor spores in cracks or crevices. For high-risk areas, such as kitchens or hospitals, use HEPA-filtered vacuums and microfiber cloths to physically remove spores, followed by disinfection with fungicidal agents.
Finally, temperature and UV light play pivotal roles in fungal spore survival. Alternaria, a common outdoor mold, can survive on surfaces for months in cool, dark environments but is rapidly inactivated by direct sunlight. UV-C light, in particular, is highly effective at disrupting fungal DNA, reducing spore viability within minutes. For indoor spaces, consider UV-C sanitizing devices, especially in areas prone to mold or mildew. However, ensure proper safety measures, as UV-C light can be harmful to humans and pets. By leveraging these species-specific traits, you can develop targeted strategies to minimize fungal spore survival and maintain healthier environments.
Mastering the Art of Jumping in Spore: A Comprehensive Guide
You may want to see also
Explore related products

Cleaning Effectiveness: Proper cleaning methods reduce spore lifespan on surfaces significantly
Fungal spores can survive on surfaces for weeks, months, or even years, depending on environmental conditions. However, their lifespan is not set in stone. Proper cleaning methods can significantly reduce their viability, minimizing the risk of fungal growth and associated health issues. This is particularly crucial in environments prone to moisture, such as bathrooms, kitchens, and basements, where fungi thrive.
Analytical Perspective:
The effectiveness of cleaning lies in disrupting the spore’s protective outer layer and removing its nutrient sources. Fungal spores are resilient due to their hard outer walls, which shield them from harsh conditions. However, mechanical action combined with the right cleaning agents can break this barrier. For instance, scrubbing surfaces with a stiff brush or microfiber cloth physically dislodges spores, while solutions like diluted bleach (1:10 ratio of bleach to water) or vinegar (undiluted white vinegar) chemically deactivate them. Studies show that surfaces cleaned with these methods reduce spore viability by up to 99% within 24 hours, compared to untreated surfaces where spores remain viable for weeks.
Instructive Approach:
To maximize cleaning effectiveness, follow these steps:
- Pre-clean: Remove visible dirt and debris with a damp cloth to expose spores.
- Apply Solution: Use a fungicidal cleaner or homemade solution (e.g., 1 cup bleach in 1 gallon of water) and let it sit for 10 minutes to penetrate the spore’s protective layer.
- Scrub: Use a brush or abrasive pad to physically dislodge spores.
- Rinse and Dry: Wipe the surface with a clean, damp cloth, then dry thoroughly to prevent moisture buildup, which spores need to germinate.
Persuasive Argument:
Investing time in proper cleaning is not just about aesthetics—it’s a health imperative. Fungal spores can trigger allergies, asthma, and infections, especially in vulnerable populations like children, the elderly, and immunocompromised individuals. For example, *Aspergillus* spores, commonly found on damp surfaces, can cause severe respiratory issues if inhaled. By adopting rigorous cleaning practices, you not only shorten the lifespan of spores but also create a safer living environment.
Comparative Insight:
While wiping surfaces with a dry cloth or using water alone may remove some spores, it often leaves many intact. In contrast, combining mechanical action with fungicidal agents ensures a more thorough eradication. For instance, a study comparing dry dusting to bleach cleaning found that the latter reduced spore counts by 95% more effectively. Similarly, microfiber cloths outperform traditional rags due to their ability to trap smaller particles, including spores.
Practical Tips:
- Clean high-risk areas (e.g., shower tiles, refrigerator gaskets) weekly.
- Use HEPA-filtered vacuums to prevent spore dispersal during cleaning.
- Store cleaning tools separately to avoid cross-contamination.
- Monitor humidity levels (ideally below 50%) to discourage spore germination.
By implementing these strategies, you can drastically reduce the lifespan of fungal spores on surfaces, transforming your cleaning routine into a powerful tool for health and hygiene.
Can Mold Spores Cause a Burning Sensation in Your Throat?
You may want to see also

Indoor vs. Outdoor Survival: Spores live longer indoors due to controlled, stable environments
Fungal spores are remarkably resilient, capable of surviving on surfaces for extended periods. However, their longevity varies significantly between indoor and outdoor environments. Indoors, where conditions are often controlled and stable, spores can persist for months or even years. This is due to the absence of extreme temperature fluctuations, direct sunlight, and precipitation, all of which can degrade spores outdoors. For instance, a study found that *Aspergillus* spores remained viable on drywall for over 12 months in a temperature-controlled setting, whereas outdoor exposure reduced their viability to mere weeks.
To understand why spores thrive indoors, consider the factors that influence their survival. Indoors, humidity levels are often maintained within a narrow range, typically between 30% and 60%, which is ideal for spore longevity. In contrast, outdoor humidity can fluctuate drastically, leading to desiccation or excessive moisture that damages spore structures. Additionally, indoor air circulation is generally limited, reducing the likelihood of spores being dispersed or dislodged from surfaces. Practical tip: Regularly monitor indoor humidity levels and use dehumidifiers in damp areas to discourage spore survival.
From a comparative perspective, outdoor environments present challenges that shorten spore lifespan. UV radiation from sunlight is a potent spore killer, breaking down their cellular components. Rain and wind further contribute to their demise by physically washing them away or causing mechanical damage. For example, *Cladosporium* spores, common outdoors, lose viability within 2–4 weeks under direct sunlight. Indoors, however, these same spores can survive on carpet fibers for up to 6 months. This stark difference highlights the protective nature of indoor environments.
For those concerned about fungal spore exposure, especially in indoor settings, proactive measures are essential. Regular cleaning with HEPA-filtered vacuums and microfiber cloths can remove spores from surfaces. In high-risk areas like bathrooms and basements, antifungal solutions (e.g., diluted bleach or vinegar) can be applied to disinfect surfaces. Caution: Avoid over-humidifying indoor spaces, as this creates an ideal breeding ground for mold and spores. Instead, aim for a balanced humidity level and ensure proper ventilation to disrupt spore accumulation.
In conclusion, the controlled and stable conditions of indoor environments provide an ideal sanctuary for fungal spores, allowing them to outlive their outdoor counterparts by significant margins. Understanding this dynamic is crucial for managing indoor air quality and preventing mold-related health issues. By taking targeted steps to modify indoor conditions and reduce spore presence, individuals can mitigate the risks associated with prolonged spore survival.
Do Sporophytes Produce Spores? Unraveling the Role in Plant Reproduction
You may want to see also
Frequently asked questions
Fungal spores can survive on surfaces for weeks to years, depending on the species, environmental conditions, and surface type.
Fungal spores are highly resilient and can remain viable on dry surfaces for extended periods, often months to years, unless exposed to extreme conditions.
Regular cleaning can remove fungal spores, but they are resistant to many disinfectants. Specialized antifungal agents or thorough mechanical removal is often necessary to eliminate them.
Yes, extreme temperatures (very hot or very cold) can reduce the viability of fungal spores, but many can survive a wide range of temperatures, especially in dormant states.
High humidity can prolong the survival of fungal spores, as they thrive in moist environments. Low humidity may reduce their viability over time but does not always eliminate them.

























